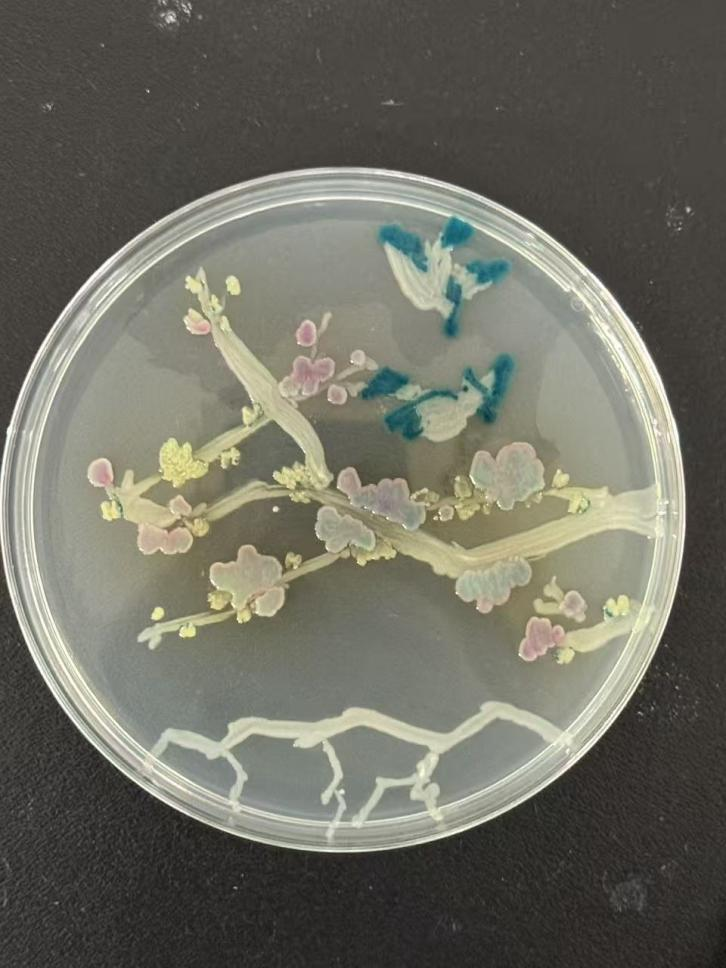

2025年11月16日,best365官网在尚德楼C309顺利开展第六届“皿”上添花艺术大赛。本次活动由校团委主办,best365官网承办。恰逢best365官网办学四十周年,这场以微生物为笔、培养皿为卷的创意盛会,既是公司学科特色与美育实践的深度融合,更是生工学子为“四秩生工”献上的别样祝福。
此次活动由实验中心韦策老师、公司团委副书记贺鑫老师指导,best365官网员工会科技创新部主持。活动筹备阶段,韦策老师细心挑选了多种色系的荧光蛋白菌株,备齐培养皿、接种针等实验器材,为比赛提供了充足保障。比赛现场,参赛者们热情满满,在科创部部员的协助下,拿起接种针蘸取菌液,在小小的培养皿上尽情挥洒创意,每一幅作品都充满巧思与温度。
活动结束后,工作人员将所有参赛作品密封标记,移入恒温光照培养箱中。经过三天的耐心培养,原本的菌液痕迹逐渐生长蔓延,绽放出柔和的荧光,一幅幅生动鲜活的“菌绘”作品跃然皿上:菌落细细勾勒,醒目的“40”字样清晰呈现,一笔一画都承载着对公司四十载春秋的诚挚祝福;微生物巧妙排布,经典的校徽形象精准复刻,交织着生工学子的专业坚守与深厚情怀;粉菌晕染成瓣,蓝菌轻描双翅,蝴蝶绕花的景致描绘了微观世界的烂漫春天。经过综合评定,制药2501李晨明,生工2501张玥,生工2501周奕辰同学的作品脱颖而出,获一等奖;生工2501赵晟,制药国2502杨张婷等同学获二等奖;生工(英才)2501丁天悦,电气中西2501管艺津等同学获三等奖。
此次“皿”上添花艺术大赛,以学科特色为纽带,让同学们感受到了科研的趣味性与创造力。四秩弦歌不辍,初心薪火相传,这场充满创意的学科活动,为公司办学四十周年系列庆典增添了灵动色彩,也在青年学子心中播下了传承学科精神、探索科研之美的种子。
图文:牛妤珊 曹旻珏 贺鑫 审核:徐元龙 单位:best365官网